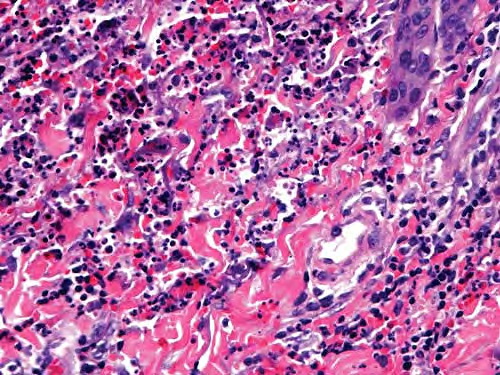

|
Neutrophilic dermatosis= الجلاد بالمعتدلات |
|
|
Sweets Syndrome and Sweets Like Neutrophilic Dermatosis
Dr. R. D. Sweet described in 1964 a disease process, which he termed "acute febrile neutrophilic dermatosis," that was characterized by abrupt onset of fever, leukocytosis, and erythematous plaques infiltrated by neutrophils . This condition typically occurs in middle-aged women after nonspecific infections of the respiratory or gastrointestinal tract. The lesions tend to be found on the face or extremities and only rarely involve the trunk and respond to steroid treatment. Despite the numerous neutrophils, the lesions are sterile. Vesicles and pustules may also arise. Involvement of noncutaneous sites, such as eyes, joints, oral mucosa, and visceral sites (lungs, liver, kidneys), has been reported. A variety of disorders have been associated with neutrophilic dermatoses similar to those seen in Sweet's syndrome (Sweet's-like neutrophilic dermatosis). About 20% of cases are associated with malignancy. Cutaneous eruptions with inflammatory vascular reactions, which on occasion simulate the lesions of Sweet's syndrome, may also occur in association with hereditary periodic fever, which comprises several syndromes including familial Mediterranean fever, the hyper-lgD syndrome, and the tumor necrosis factor receptor-associated periodic syndrome .
|
|
Histopathology.
Typically, a dense perivascular infiltrate composed largely of neutrophils is seen assuming a bandlike distribution throughout the papillary dermis . Some of the neutrophils may show nuclear fragmentation (leukocytoclasis). In addition, the infiltrate may contain scattered lymphocytes and histiocytes and occasional eosinophils. The density of the infiltrate varies and may be limited in a small proportion of cases. Vasodilation and swelling of endothelium with moderate erythrocyte extravasation and prominent edema of the upper dermis are characteristic. In some instances, subepidermal blister formation may result. Extensive vascular damage is not a feature of Sweet's syndrome. The histologic appearance varies depending on the stage of the process. In later stages, lymphocytes and histiocytes may predominate. Sweet's-like neutrophilic dermatoses often show a similar histologic picture. However, the reaction pattern may on occasion be quite different, for instance, manifesting as deep subcutaneous localized suppurative panniculitis. The infiltrate of Sweet's syndrome is not characteristic enough to exclude infection on histologic findings alone. As always, to arrive at the correct interpretation of a neutrophilic infiltrate, cultures need to be obtained and special stains need to be performed to exclude an infectious etiology.
|
|
Pathogenesis. Sweet's syndrome's etiology is unknown but is thought to be a hypersensitivity reaction. The three major concepts that have been discussed are immune complex vasculitis, altered T-cell activation, and altered function of neutrophils. All lack, however, sufficient experimental support. The vascular alterations seen in Sweet's syndrome may be secondary to the massive extravasation of activated neutrophils. Direct immunofluorescence studies are generally negative in Sweet's syndrome .
|
|